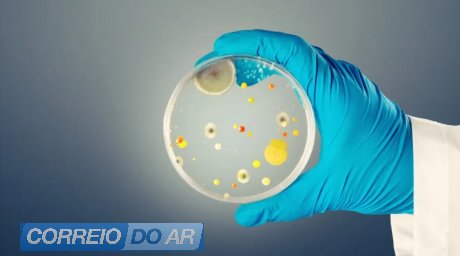

Nacional | Candidozyma auris
Quinta-feira, 25 de Setembro de 2025
Vírus mortal Candida auris se espalha pela Europa e acende alerta global
Identificado pela primeira vez em 2009, o fungo Candida auris já atinge mais de 40 países e mostra resistência a tratamentos comuns. Potencialmente letal para pacientes vulneráveis, sobrevive em superfícies hospitalares e representa um desafio crescente para a saúde pública global
Candida auris é um fungo mortal que tem preocupado autoridades de saúde em todo o mundo. Ele se espalha rapidamente em hospitais e já foi identificado em mais de 40 países, incluindo Portugal, onde houve quatro casos confirmados entre 2013 e 2023. No Reino Unido, os números chamam a atenção: entre novembro de 2024 e abril de 2025, foram registrados 134 casos, um aumento de 23% em relação ao semestre anterior.
Embora possa causar sintomas leves em pessoas saudáveis, o Candida auris é extremamente perigoso em pacientes com imunidade comprometida. Quando atinge a corrente sanguínea e órgãos vitais, pode ser letal: estima-se que entre 30% e 60% dos infectados morram.
O fungo foi identificado pela primeira vez no Japão, em 2009, e preocupa por sua alta resistência. Ele sobrevive por longos períodos em superfícies hospitalares e, muitas vezes, não responde a tratamentos antifúngicos de primeira linha. Por isso, pode se espalhar de forma silenciosa em hospitais, inclusive a partir de pacientes assintomáticos.
Entre os sintomas estão infecções no sangue, cérebro e outros órgãos, mas a detecção precoce é difícil. O Candida auris se transmite principalmente pelo contato com superfícies e equipamentos médicos contaminados, além de contato direto com pessoas infectadas.
As medidas de prevenção são semelhantes às de outras infecções hospitalares: higienização frequente das mãos, limpeza rigorosa dos ambientes, isolamento de pacientes infectados e uso de equipamentos descartáveis.
De acordo com o Centro Europeu de Prevenção e Controle de Doenças, a União Europeia e o Espaço Econômico Europeu já registraram mais de 4 mil casos. Em 2023, houve um salto significativo, com 1.346 infecções confirmadas em 18 países, destacando o risco crescente de surtos hospitalares.
Fonte: Notícias ao Minuto